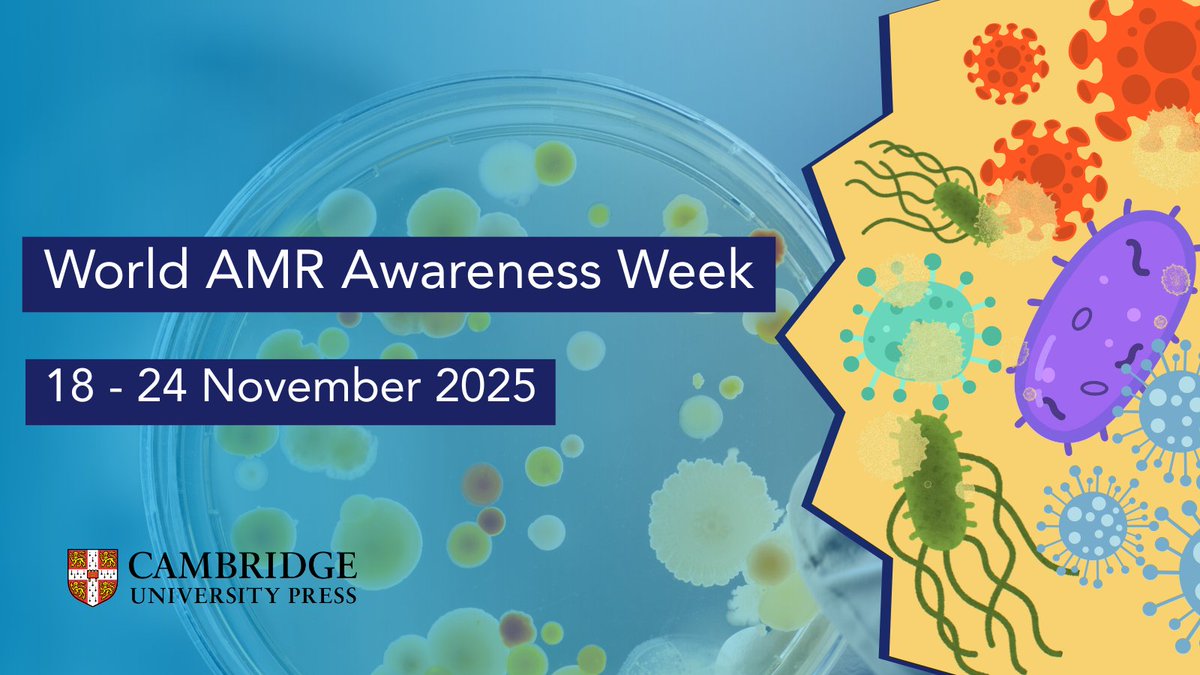
For World Antimicrobial Resistance Awareness Week (18–24 Nov), <a href="/CambridgeUP/">Cambridge University Press</a> is highlighting key research and books on tackling one of today’s most urgent health challenges.

Explore our AMR collection: cup.org/49ofZ5q

#WAAW2025 #AMR <a href="/WHO/">World Health Organization (WHO)</a>

Cambridge UP - Anthropology & Sociology
@cup_anthro_soc
Follow us for the latest news and offers from @CambridgeUP's Anthropology and Sociology titles.
ID: 380620617
http://www.cambridge.org/alerts 26-09-2011 23:29:32
2,2K Tweet
6,6K Takipçi
1,1K Takip Edilen

Call for Papers: #PublicHumanities invites submissions on Rights of Nature. How can seeing nature as a living being reshape human relations, resist extractivism, & inspire climate and social justice worldwide? Learn more: cup.org/4mY4nJt Zoe Hope Bulaitis / @zoebulaitis.bsky.social Jeffrey R. Wilson





For World Antimicrobial Resistance Awareness Week (18–24 Nov), Cambridge University Press is highlighting key research and books on tackling one of today’s most urgent health challenges. Explore our AMR collection: cup.org/49ofZ5q #WAAW2025 #AMR World Health Organization (WHO)

Call for Papers: #PublicHumanities invites submissions on the cultural politics of AI in education, language, and identity. How is AI shaping how we teach, speak, and imagine the self? Deadline: 1 Dec 2025 More info ➡️ cup.org/3Hk2Puz Zoe Hope Bulaitis / @zoebulaitis.bsky.social Jeffrey R. Wilson











📣 #PublicHumanities invites papers for an issue focused on #Solidarity in global health — exploring its meanings, challenges, and transformative potential from a global perspectives. Find out more: cup.org/3T6kRmr Editors-in-Chief Zoe Hope Bulaitis / @zoebulaitis.bsky.social and Jeffrey R. Wilson


















